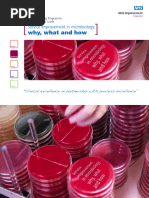

0% found this document useful (0 votes)
39 views2 pagesPathology Case Study Institute
Hereford Hospitals NHS Trust has implemented Lean Thinking to reduce turnaround times in pathology, addressing significant delays in test results that impact patient discharge. The initiative led to a 40% reduction in turnaround time and improved efficiency, ultimately saving costs and enhancing patient care. Key improvements included better resource management, streamlined processes, and reduced waste, resulting in quicker clinical decision-making and improved staff morale.
Uploaded by
gainakaCopyright
© © All Rights Reserved
We take content rights seriously. If you suspect this is your content, claim it here.
Available Formats
Download as PDF, TXT or read online on Scribd
0% found this document useful (0 votes)
39 views2 pagesPathology Case Study Institute
Hereford Hospitals NHS Trust has implemented Lean Thinking to reduce turnaround times in pathology, addressing significant delays in test results that impact patient discharge. The initiative led to a 40% reduction in turnaround time and improved efficiency, ultimately saving costs and enhancing patient care. Key improvements included better resource management, streamlined processes, and reduced waste, resulting in quicker clinical decision-making and improved staff morale.
Uploaded by
gainakaCopyright
© © All Rights Reserved
We take content rights seriously. If you suspect this is your content, claim it here.
Available Formats
Download as PDF, TXT or read online on Scribd